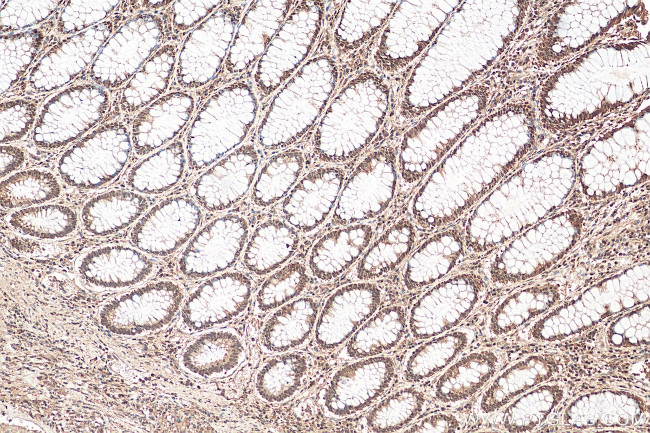
GATA6 Antibody in Immunohistochemistry (Paraffin) (IHC (P))

Search
Proteintech
GATA6 Polyclonal Antibody
{{$productOrderCtrl.translations['antibody.pdp.commerceCard.promotion.promotions']}}
{{$productOrderCtrl.translations['antibody.pdp.commerceCard.promotion.viewpromo']}}
{{$productOrderCtrl.translations['antibody.pdp.commerceCard.promotion.promocode']}}: {{promo.promoCode}} {{promo.promoTitle}} {{promo.promoDescription}}. {{$productOrderCtrl.translations['antibody.pdp.commerceCard.promotion.learnmore']}}
产品信息
55435-1-AP
种属反应
已发表种属
宿主/亚型
分类
类型
抗原
偶联物
形式
浓度
规格
纯化类型
保存液
内含物
保存条件
运输条件
靶标信息
The GATA6 gene encodes a member of the GATA family of zinc-finger transcription factors, which are critical in regulating gene expression during development. GATA6 plays a crucial role in the differentiation and development of multiple tissues, including the heart and gastrointestinal tract, by interacting with other transcriptional regulators through its zinc-finger domains. This gene influences signaling pathways that drive epithelial-to-mesenchymal transitions (EMTs) and immune surveillance, which are essential processes in maintaining tissue homeostasis and countering tumor progression. In the respiratory tract, GATA6 is essential for the differentiation of lung epithelial cells, impacting the expression of WNT7B and surfactant proteins, vital for proper lung function. Furthermore, studies suggest that GATA6 contributes to an immune-enriched phenotype linked to favorable prognostic outcomes in certain cancers, indicating its potential role in mitigating metastatic propensity by enhancing immune response and surveillance against tumorous cells.
仅用于科研。不用于诊断过程。未经明确授权不得转售。
生物信息学
蛋白别名: ASD9; AVSD5; GATA-binding factor 6; GATA-binding protein 6; Transcription factor GATA-6
基因别名: AA410133; GATA-6; GATA6
UniProt ID: (Human) Q92908, (Mouse) Q61169
Entrez Gene ID: (Human) 2627, (Mouse) 14465